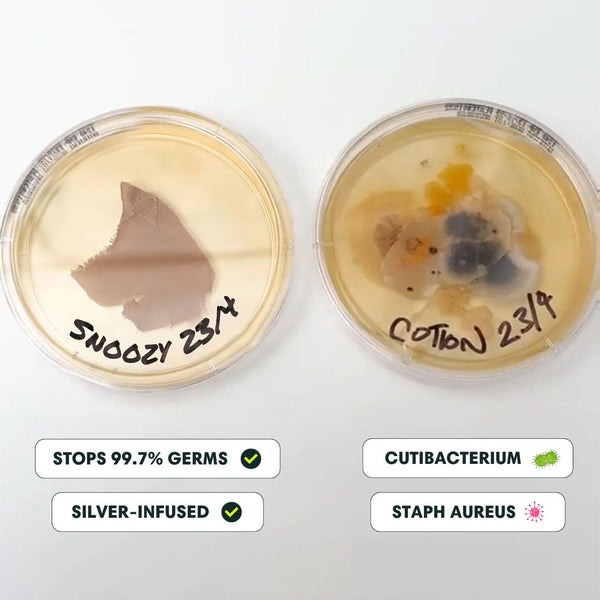

Why Your Skin Isn’t Getting Better
You do everything right—wash your face, stay hydrated, even watch what you eat—but your skin still isn’t clear.
The real problem? Your pillowcase. It collects oil, dirt, and bacteria every night, undoing your efforts while you sleep.
The Cause
The hidden problem
affecting your skin
Acne has many causes—hormones, diet, stress, genetics—but bacteria and irritation make it worse.
Your pillowcase rubs bacteria, sweat, and dead skin back onto your face every night. Washing it daily is the only way to stop the cycle—but who has time for that.
And cotton? It absorbs oils and skincare while creating friction that leads to irritation, redness, and premature aging.
You can’t control everything that affects your skin—but this is one change that makes a differen
The Solution
The world’s first clinically proven anti-acne pillowcase
Your skin spends 8 hours a night against your pillow—shouldn’t it be clean? Skin Savior is designed to keep bacteria away and reduce irritation, so your skin gets the fresh start it deserves.
Its antimicrobial silver technology eliminates 99.7% of bacteria, keeping your pillow clean night after night. Unlike cotton, it won’t absorb moisture or skincare, so your skin stays hydrated and protected.
Soft, breathable, and made for healthier skin. The simplest switch—with real results.
CLINICALLY PROVEN & TRUSTED BY EXPERTS
Infused with silver ions that prevent 99.7% and clinically-proven to clear your skin.
94%
of users experienced more clear skin.
87%
of users reported less redness.
95%
of users said they had fewer breakouts and blackheads.




Kills 99.7% of bacteria
Infused with silver to kill almost all acne-causing bacteria
Clearer, acne-free skin
Dermatologist-approved to actively restore skin overnight
Prevents clogged pores
Wicks away excess moisture and keeps oil buildup at bay
Ultra hypoallergenic
OEKO-TEX® certified and naturally antibacterial
Us vs Them
It’s what touches your skin that counts. Skin Savior™ works overnight to keep your skin clear, hydrated, and irritation-free—no bacteria, no breakouts, no unnecessary bs.

If you don’t see results in 150 days, we’ll refund you
Step 1: Track your skin’s progress
Take a photo of your skin before switching to Skin Savior™, then check in every few weeks. You might be surprised at how much clearer and healthier your skin looks!
Step 2: Use it every night
Sleep on your Skin Savior™ eucalyptus silk pillowcase every night—consistency is key. Unlike cotton, it won’t absorb your skincare or harbor acne-causing bacteria.
Step 3: Stick to it for 150 days
Give your skin time to reset. Our customers report the best results after consistent use for 150 nights—less irritation, fewer breakouts, and smoother, healthier skin.

FAQ for Restful Nights
From curious to confident—your questions answered.
Most people sleep on a cotton pillowcase, but did you know that after just 3 days there are as many bacteria on your pillowcase as there are on a toilet seat? Our eucalyptus silk pillowcases are infused with silver ions, eliminating 99.7% of all bacteria. Eucalyptus silk is also naturally super soft, cooling, and hypoallergenic.
Eucalyptus silk offers superior quality and durability compared to traditional silk, while also being eco-friendly and cruelty-free. It's a more affordable option that doesn't compromise on luxury, known for its natural softness and cooling properties. Choosing eucalyptus silk supports a sustainable and compassionate lifestyle, reflecting modern values of ethical consumption.
If you want to achieve better skin. health, and sleep, then the first step to take is switching from cotton to silk. Sleeping on our Skin Savior™ contributes to clean, cool, and healthy sleep. Additionally, our vegan silk is a more sustainable and environmentally friendly option, reducing water usage and minimizing environmental impact compared to traditional silk production.
Sure! Unlike other skincare products, our products are suitable for all skin types.
They sure have! Our products are SGS certified. This is the largest testing organization worldwide. The tests show that the silver ions are still effective after 51 washes!
To produce 1 kilo of silk, 6.000 liters of water is needed. And when it comes to cotton, 20.000 liters of water is used for just 1 kilo.
Whereas to produce 1 kilo of eucalyptus silk, 200 times less water is used. Making it much more sustainable and better for the environment. We strive to minimize the impact on the environment with our brand. We are 100% safe and certified. We have passed all SGS tests, and inspections and our products are OEKO-Tex certified.














































































